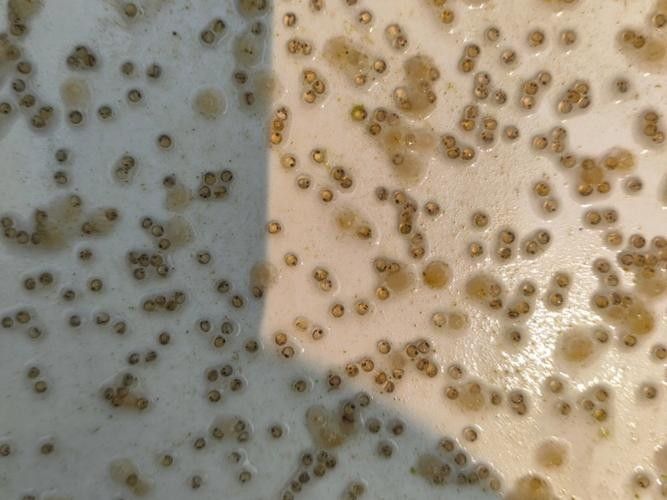
金龍魚的卵是什么樣子的

金龍魚的卵是什么樣子的
金龍魚的卵是什么樣子的





















 展開
展開
 龍魚的孵化繁殖過程——從金龍魚魚卵到小龍魚魚苗的成長過程高清組圖魚之游水
龍魚的孵化繁殖過程——從金龍魚魚卵到小龍魚魚苗的成長過程高清組圖魚之游水
 超珍貴資料|龍魚從卵到龍的67天詳細(xì)過程,主人暖心記錄,愛意滿滿!zi li
超珍貴資料|龍魚從卵到龍的67天詳細(xì)過程,主人暖心記錄,愛意滿滿!zi li
 銀龍魚排卵是什么樣子(金龍魚排卵)www.lwhy5.com
銀龍魚排卵是什么樣子(金龍魚排卵)www.lwhy5.com
 龍魚是怎么繁殖的呢養(yǎng)魚老道
龍魚是怎么繁殖的呢養(yǎng)魚老道
 發(fā)財(cái)了!價(jià)值上萬的金龍魚生寶寶,男子心里美滋滋,下一秒?yún)s傻眼半斤今天吃什么龍魚產(chǎn)卵抖音編輯
發(fā)財(cái)了!價(jià)值上萬的金龍魚生寶寶,男子心里美滋滋,下一秒?yún)s傻眼半斤今天吃什么龍魚產(chǎn)卵抖音編輯
金龍魚卵需要多久換水?
金龍魚卵多久能孵化出小魚?
如何區(qū)分金龍魚卵是否受精?
金龍魚的卵具有以下顯著特征:
外觀形態(tài)
卵呈橘黃色或金黃色,直徑約12-15毫米,形似彈珠,表面有金屬光澤,尤其在光線照射下會(huì)閃爍耀眼光芒。產(chǎn)卵時(shí)卵粒會(huì)從雌魚腹部粒粒落下12。產(chǎn)卵行為
雌魚產(chǎn)卵后,雄魚會(huì)立即將卵含入口中孵化,每條雄魚一次可含40-50粒卵。若雄魚無法含下全部卵,雌魚可能吞食剩余卵或暫時(shí)保護(hù)13。特殊習(xí)性
龍魚屬于口孵魚類,卵在雄魚口中孵化約60天,幼魚出卵后仍會(huì)在雄魚口中進(jìn)出活動(dòng)約30天,直至完全獨(dú)立34。

展開
展開- 稀有性
龍魚每次產(chǎn)卵量較少(通常20-60粒),且因環(huán)境干擾可能導(dǎo)致卵被吞食,實(shí)際孵化成功率較低15。卵的珍貴性也與其成魚的高價(jià)值相關(guān)56。
 龍魚的孵化繁殖過程——從金龍魚魚卵到小龍魚魚苗的成長過程高清組圖魚之游水
龍魚的孵化繁殖過程——從金龍魚魚卵到小龍魚魚苗的成長過程高清組圖魚之游水 超珍貴資料|龍魚從卵到龍的67天詳細(xì)過程,主人暖心記錄,愛意滿滿!zi li
超珍貴資料|龍魚從卵到龍的67天詳細(xì)過程,主人暖心記錄,愛意滿滿!zi li 銀龍魚排卵是什么樣子(金龍魚排卵)www.lwhy5.com
銀龍魚排卵是什么樣子(金龍魚排卵)www.lwhy5.com 龍魚是怎么繁殖的呢養(yǎng)魚老道
龍魚是怎么繁殖的呢養(yǎng)魚老道 發(fā)財(cái)了!價(jià)值上萬的金龍魚生寶寶,男子心里美滋滋,下一秒?yún)s傻眼半斤今天吃什么龍魚產(chǎn)卵抖音編輯
發(fā)財(cái)了!價(jià)值上萬的金龍魚生寶寶,男子心里美滋滋,下一秒?yún)s傻眼半斤今天吃什么龍魚產(chǎn)卵抖音編輯金龍魚卵需要多久換水?
金龍魚卵多久能孵化出小魚?
如何區(qū)分金龍魚卵是否受精?
推薦閱讀:
魚缸用增氧泵價(jià)格是多少:魚缸增氧機(jī)-xtrac增氧機(jī)-xtrac增氧機(jī)
給大魚缸換水的頻率是固定的,而是需要根據(jù)多種因素來確定:給大魚缸換水的頻率不是固定的,而是需要根據(jù)多種因素來確定
文章版權(quán)聲明:本站文章來之全網(wǎng),如有雷同請(qǐng)聯(lián)系站長微信xlyc002 ,轉(zhuǎn)載或復(fù)制請(qǐng)以超鏈接形式并注明出處。

發(fā)表評(píng)論